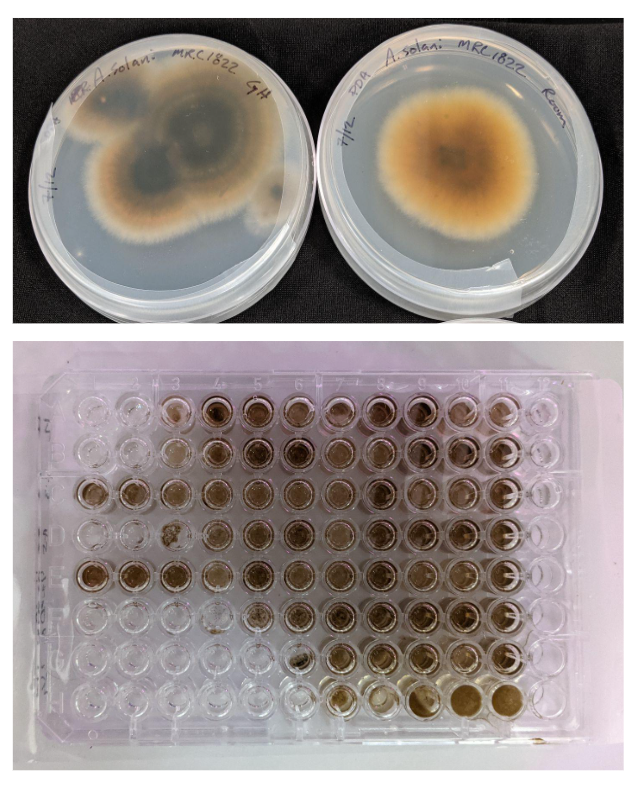

SERVICES
LAB
Precision screening and foundational data generation for early-stage discovery.
High-throughput library screening for fungicide, insecticide, herbicide, and plant health candidates
Multiple lab assays for activity validation against fungal, bacterial, insect, nematode, and weed targets
Primary screening platform establishment for novel modes of action and experimental chemistries
Basic mode of action studies across plant, insect, and fungal systems
Custom assay design, optimization, and data analysis
Microbial isolation, culture, and characterization to support discovery programs
Biosafety, APHIS, and regulatory guidance

GREENHOUSE
Translating lab results into on-plant performance insights across diverse crops.
Controlled-environment efficacy testing on soy, corn, wheat, tomato, specialty crops, and more
Lab-to-greenhouse translation and confirmation
Dose–response studies and rate-finding support
Formulation testing for stability, compatibility, and performance (foliar, soil, seed treatment)
Phytotoxicity evaluation across crops and developmental stages
Development of greenhouse protocols and disease/nematode/insect challenge models


FIELD
Real-world validation to guide product development and regulatory decision-making.
Coordination and management of domestic and international field trials
Selection and oversight of CROs, university partners, and grower-cooperators
Field efficacy testing for fungicides, insecticides, nematicides, herbicides, and plant health products
Data review, interpretation, and recommendations for next-stage development
Support for rate refinement, product positioning, and market-fit assessments
Trial design tailored to target diseases, pests, crop production systems, and geography

